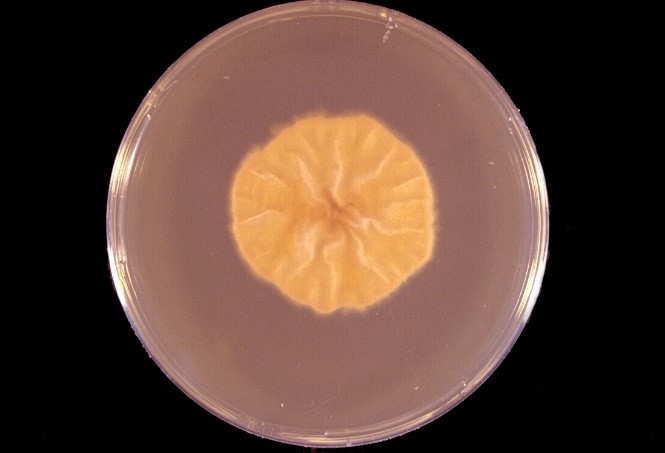

Trichophyton spp
В белоруссии заблокировали ютуб
Дубовые бочки какие лучше
Получение накопительной пенсии отзывы
Анальгезирующее комбинированное средство
Раздать сеть с айфона
Для чего используют hdmi кабель
Писатели которые написали сказки
Новая модель mercedes
Gigabyte gtx 1660 oc отзывы
Паром стрелка широкий лог
Шланги для кондиционера авто
Диз из бравла
Активный уксусный кислота
Trichophyton spp 117 фотографий